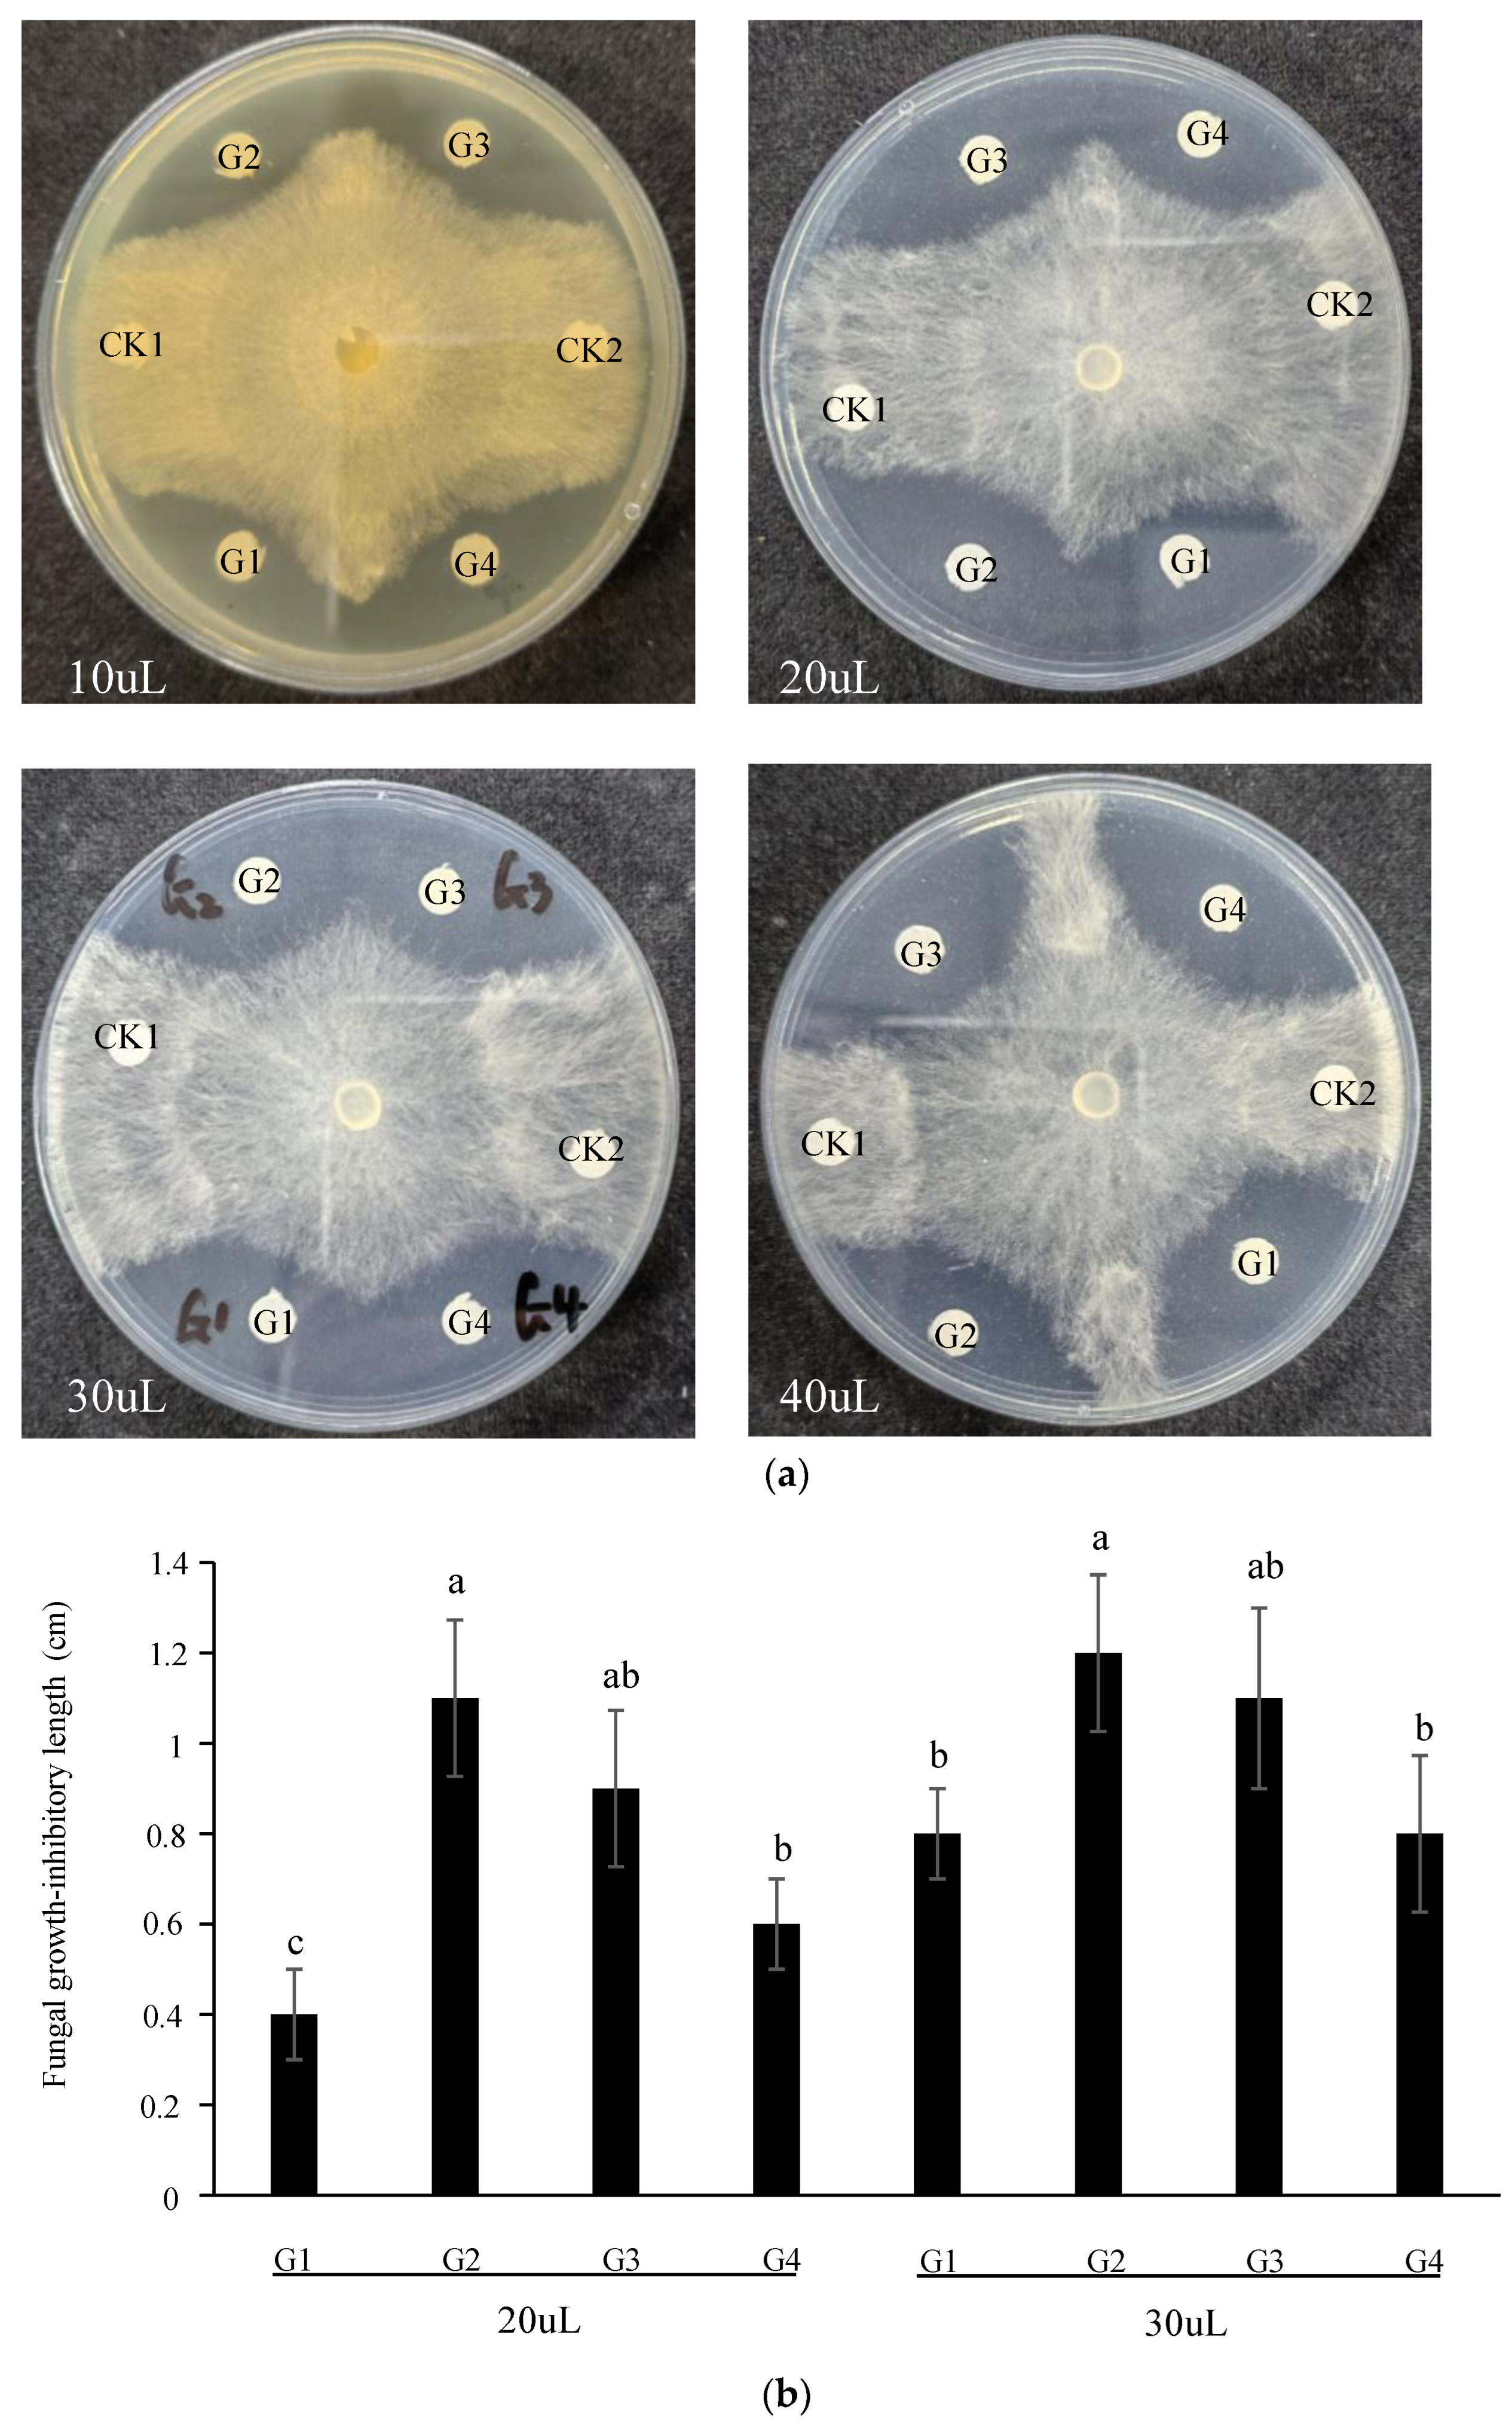
Jof 10 00033 g002

Ectopic Expression of Gastrodia Antifungal Protein in Rice Enhances Resistance to Rice Sheath Blight Disease
Abstract
:1. Introduction
2. Materials and Methods
2.1. Rice Materials
2.2. Bioinformatic Analysis of GAFP Genes
2.3. Prokaryotic Expression and Purification of GAFPs
2.4. Generation of GAFP Transgenic Rice Lines
2.5. In Vitro Antifungal Activity Assay for GAFPs
2.6. R. solani Culture, Plant Inoculation, and Evaluation
2.7. Reverse Transcription-Quantitative PCR (RT-qPCR) Analysis for Transgene Expression in Transgenic Rice
2.8. Western Blotting Analysis for Transgene Expression in Transgenic Rice
2.9. Evaluation of Agronomic Traits
2.10. Data Analysis
3. Results
3.1. GAFP Genes Are Mainly Present in Monocotyledonous Plants of the Orchidaceae Family
3.2. GAFPs Proteins Inhibit R. solani Growth on Plates
3.3. Transgenic GAFPs Rice Plants Were Generated and Verified
3.4. Transgenic GAFPs Rice Lines Display Enhanced Resistance to R. solani
3.5. Most GAFP Transgenic Lines Display No Significant Differences from Wild-Type Controls in Major Agronomic Traits
3.6. Inappropriately High Levels of GAFP Expression May Result in Shorter Plants and Other Agronomic Trait Changes
4. Discussion
4.1. Different GAFP Genes May Have Different Effects against Different Pathogens
4.2. GAFP Genes Carry High Values in the Breeding against Rice ShB Disease
Supplementary Materials
Author Contributions
Funding
Institutional Review Board Statement
Informed Consent Statement
Data Availability Statement
Acknowledgments
Conflicts of Interest
References
- Liao, H.; Xiao, L.; Wang, H. Brief analysis of the occurrence history and evolution causes of rice sheath blight. Guangxi Plant Prot. 1997, 10, 35–38. [Google Scholar]
- Zuo, S.; Zhang, Y.; Chen, Z.; Chen, X.; Pan, X. Current progress in genetics and breeding in resistance to rice sheath blight. Scienila Sin. Vitae 2010, 40, 1014–1023. [Google Scholar]
- Cu, R.; Mew, T.; Cassman, K.; Teng, P. Effect of sheath blight on yield in tropical, intensive rice production system. Plant Dis. 1996, 80, 1103–1108. [Google Scholar] [CrossRef]
- Huang, S.; Wang, L.; Huang, W. Theory and practice of fool prevention and control technology of the main diseases and insect pests in rice. China Rice 2009, 5, 48–51. [Google Scholar]
- Chen, B. Resistance Evaluation of Fujian Rice Germplasm Resources to Sheath Blight and Broad-Spectrum Resistance of Transgenic Rices. Master’s Thesis, Fujian Agriculture and Forestry University, Fuzhou, China, 2010. [Google Scholar]
- Xiang, X.; Wang, S.; He, L.; Li, J.; Li, P. The Finding of a Mutant Material with High Resistance to Rice Sheath Blight and Preliminary Genetic Analysis. Acta Agron. Sin. 2005, 31, 1236–1238. [Google Scholar]
- Liu, Y.; Chen, Z.; Ji, J.; Liu, Y. Resistance of rice blight in main and regional test varieties in Jiangsu Province. Jiangsu Agric. Sci. 2006, 34, 27–28. [Google Scholar]
- Chen, Y. Mapping Sheath Blight Resistance Quantitative Trait Loci in Rice; Chinese Academy of Agricultural Sciences: Beijing, China, 2019. [Google Scholar]
- Pinson, S.R.M.; Oard, J.H.; Groth, D.; Miller, R.; Marchetti, M.A.; Shank, A.R.; Jia, M.; Jia, Y.; Fjellstrom, R.G.; Li, Z. Registration of TIL:455, TIL:514, and TIL:642, three rice germplasm lines containing introgressed sheath blight resistance alleles. J. Plant Regist. 2008, 2, 251–254. [Google Scholar] [CrossRef]
- Jia, Y.; Liu, G.; Correa-Victoria, F.J.; McClung, A.M.; Oard, J.H.; Bryant, R.J.; Jia, M.; Correll, J.C. Registration of four rice germplasm lines with improved resistance to sheath blight and blast diseases. J. Plant Regist. 2012, 6, 95–100. [Google Scholar] [CrossRef]
- Li, Z.; Pinson, S.R.M.; Marchetti, M.A.; Stansel, J.W.; Park, W.D. Characterization of quantitative trait loci (QTLs) in cultivated rice contributing to field resistance to sheath blight (Rhizoctonia solani). Theor. Appl. Genet. 1995, 91, 382–388. [Google Scholar] [CrossRef]
- Zeng, Y.; Li, X.; Ma, L.; Ji, Z.; Yang, C. Research progress on mapping of gene conferring resistance to sheath blight and exploitation of resistance resources in rice. Chin. J. Rice Sci. 2010, 24, 544–550. [Google Scholar]
- Eizenga, G.C.; Jia, M.; Pinson, S.R.; Gasore, E.R.; Prasad, B. Exploring sheath blight quantitative trait loci in a Lemont/O. meridionalis advanced backcross population. Mol. Breed. 2015, 35, 140. [Google Scholar] [CrossRef]
- Zuo, S.; Zhang, Y.; Yin, Y.; Li, G.; Zhang, G.; Wang, H.; Chen, Z.; Pan, X. Fine-mapping of qSB-9TQ, a gene conferring major quantitative resistance to rice sheath blight. Mol. Breed. 2014, 34, 2191–2203. [Google Scholar] [CrossRef]
- Jiang, S.; Wang, C.; Shu, C.; Zhou, E. Cloning and expression analysis of RsPhm gene in Rhizoctonia solani AG-1IA of rice sheath blight pathogen. Chin. J. Rice Sci. 2018, 32, 111–118, (In Chinese with English Abstract). [Google Scholar]
- Molla, K.A.; Karmakar, S.; Molla, J.; Bajaj, P.; Varshney, R.K.; Datta, S.K.; Datta, K. Understanding sheath blight resistance in rice: The road behind and the road ahead. Plant Biotechnol. J. 2020, 18, 895–915. [Google Scholar] [CrossRef]
- Naveenkumar, R.; Anandan, A.; Prabhukarthikeyan, S.R.; Mahender, A.; Sangeetha, G.; Vaish, S.S.; Singh, P.K.; Hussain, W.; Ali, J. Dissecting genomic regions and underlying sheath blight resistance traits in rice (Oryza sativa L.) using a genome-wide association study. Plant Direct. 2023, 7, e540. [Google Scholar] [CrossRef]
- Wang, A.; Shu, X.; Jing, X.; Jiao, C.; Chen, L.; Zhang, J.; Ma, L.; Jiang, Y.; Yamamoto, N.; Li, S.; et al. Identification of rice (Oryza sativa L.) genes involved in sheath blight resistance via a genome-wide association study. Plant Biotechnol. J. 2021, 19, 1553–1566. [Google Scholar] [CrossRef]
- Li, D.; Zhang, F.; Pinson, S.R.; Edwards, J.D.; Jackson, A.K.; Xia, X.; Eizenga, G.C. Assessment of Rice Sheath Blight Resistance Including Associations with Plant Architecture, as Revealed by Genome-Wide Association Studies. Rice 2022, 15, 31. [Google Scholar] [CrossRef]
- Channamallikarjuna, V.; Sonah, H.; Prasad, M.; Rao, G.J.N.; Chand, S.; Upreti, H.C.; Singh, N.K.; Sharma, T.R. Identification of major quantitative trait loci qSBR11-1 for sheath blight resistance in rice. Mol. Breed. 2010, 25, 155–166. [Google Scholar] [CrossRef]
- Sun, X.; Lu, D.; OuYang, L.; Hu, L.; Bian, J.; Peng, X.; Chen, X.; Fu, J.; He, X.; He, H.; et al. Association Mapping and Resistant Alleles Analysis for Sheath Blight Resistance in Rice. Acta Agron. Sin. 2014, 40, 779–787. [Google Scholar] [CrossRef]
- Lu, L.; Zhou, F.; Zhou, Y.; Fan, X.; Ye, S.; Wang, L.; Chen, H.; Lin, Y. Expression profile analysisof the polygalacturonase-inhibiting protein genes in rice and their responses tophytohomones and fungal infection. Plant Cell Rep. 2012, 31, 1173–1187. [Google Scholar] [CrossRef]
- Richa, K.; Tiwari, I.M.; Kumari, M.; Devanna, B.N.; Sonah, H.; Kumari, A.; Nagar, R.; Sharma, V.; Botella, J.R.; Sharma, T.R. Functional characterization of novel chitinase genes present in the sheathblight resistance OTL: OSBR11-1 in rice line Tetep. Front. Plant Sci. 2016, 7, 244. [Google Scholar] [CrossRef] [PubMed]
- Karmakar, S.; Molla, K.A.; Chanda, P.K.; Sarkar, S.N.; Datta, S.K.; Datta, K. Green tissue-specific co-expression of chitinase andoxalate oxidase 4 genes in rice for enhanced resistance against sheath blight. Planta 2015, 243, 115–130. [Google Scholar] [CrossRef] [PubMed]
- Kim, J.K.; Jang, I.C.; Wu, R.; Zuo, W.N.; Boston, R.S.; Lee, Y.H.; Ahn, I.P.; Nahm, B.H. Co-expression of a modified maize ribosome-inactivating protein and a rice basic chitinase gene in transgenic rice plants confers enhanced resistance to sheath blight. Transgenic Res. 2003, 12, 475–484. [Google Scholar] [CrossRef] [PubMed]
- Shah, J.M.; Singh, R.; Veluthambi, K. Transgenic rice lines constitutively co-expressing tlp-D34 and chilldisplay enhancement of sheath blight resistance. Biol. Plant. 2013, 57, 351–358. [Google Scholar] [CrossRef]
- Mao, B.; Liu, X.; Hu, D.; Li, D. Co-expression of RCH10 and AGLUI confers rice resistance to fungalsheath blight Rhizoctonia solani and blast Magnorpathe oryzae and reveals impact on seed germination. World J. Microbiol. Biotechnol. 2014, 30, 1229–1238. [Google Scholar] [CrossRef] [PubMed]
- Xue, X.; Cao, Z.; Zhang, X.; Wang, Y.; Zhang, Y.; Chen, Z.; Pan, X.; Zuo, S. Overexpression of OsOSM1 enhances resistance to rice sheath blight. Plant Dis. 2016, 100, 1634–1642. [Google Scholar] [CrossRef] [PubMed]
- Pan, X.; Li, Y.; Zhang, H.; Huang, R.; Liu, W.; Ming, J.; Liu, S.; Li, X. Expression of signalling and defence-related genes mediated byover-expression of JERFl, and increased resistance to sheath blight in rice. Plant Pathol. 2014, 63, 109–116. [Google Scholar] [CrossRef]
- De Lorenzo, G.; D’Ovidio, R.; Cervone, F. The role of polygalacturonase-inhibiting proteins (PGIPs) in defense against pathogenic fungi. Annu. Rev. Phytopathol. 2001, 39, 313–335. [Google Scholar] [CrossRef]
- Hu, Z.; Yang, H.; Wang, J. The isolation and partly characteristics of a anti-fungal protein extracted from Gastrodia. Acta Bot. Yunnanica 1988, 10, 373–380. (In Chinese) [Google Scholar]
- Li, C.; Zhang, S.; Ge, Z.; Fan, F. Gastrodia Antifungal Protein cDNA Clone and Construction of Plant Expression Vector. Guizhou Agric. Sci. 2008, 36, 10–11. [Google Scholar]
- Wang, C.; Hou, J.; Zhou, M.; Xu, Q.; Zhang, X.; Ruan, P. Research Progress on Antifungal Protein of Gastrodia elate. North. Hortic. 2021, 8, 131–139. [Google Scholar]
- Wang, L. Advance on the cloning and functional analysis of disease resistance genes in rice. Hereditas 2009, 31, 999–1005. [Google Scholar]
- Chen, Y.; Wang, Y.; Zhu, G.; Shi, J.; Huang, M.; Wang, M. Acquirement of tabacco with transformation genes of GAFP (Gastrodia Antifungal Protein) and evalution of antifungal activity in vitro. J. Plan Resour. Environ. 2002, 11, 1–5. [Google Scholar]
- Cox, K.D.; Layne, D.R.; Scorza, R.; Schnabel, G. Gastrodia anti-fungal protein from the orchid Gastrodia elata confers disease resistance to root pathogens in transgenic tobacco. Planta 2006, 224, 1373–1383. [Google Scholar] [CrossRef] [PubMed]
- Wei, X.; Huang, Q.; Wang, D.; Meili, G.; Li, R.; Hu, X.; Chen, D. Preliminary screening of colored cotton for gene transformation of antifungal protein in Gastrodia elata. Xinjiang Agric. Sci. 2001, 38, 352–353. [Google Scholar]
- Wei, X.; Huang, Q.; Meng, Q.; Wang, D.; Meili, G.; Li, R.; Chen, A.; Xie, D.; Shi, W. Premiliminary Screening of Disease-resistant Transter Gene Cotton of Xinjiang Upland cotton. Xinjiang Agric. Sci. 2002, 39, 18–19. [Google Scholar]
- Chen, D.; Jian, G.; Li, R.; Zhang, Z.; Liu, F.; Yao, Z. Study on Resistance to Fusarium Wilt and Verticillium Wilt for Transgenic GAFP Colored Cotton Lines. Mol. Plant Breed. 2003, 1, 673–676. [Google Scholar]
- Liu, F.; Ma, D.; Li, R.; Li, W.; Chen, D.; Yao, Z.; Song, W.; Li, W. The Resistance Identification to Verticillium wilt and to Fusarium wilt for Transgenic GAFP Colored Cotton Lines of Xinjiang. Xinjiang Agric. Sci. 2004, 41, 244–247. [Google Scholar]
- Wang, Y.; Liang, C.; Wu, S.; Zhang, X.; Tang, J.; Jian, G.; Jiao, G.; Li, F.; Chu, C. Significant Improvement of Cotton Verticillium Wilt Resistance by Manipulating the Expression of Gastrodia Antifungal Proteins. Mol. Plant 2016, 9, 1436–1439. [Google Scholar] [CrossRef]
- Chen, C.; Chen, H.; Zhang, Y.; Thomas, H.R.; Frank, M.H.; He, Y.; Xia, R. TBtools: An integrative toolkit developed for interactive analyses of big biological data. Mol. Plant 2020, 13, 1194–1202. [Google Scholar] [CrossRef]
- Luo, X.; Lin, Z.; Chen, Z.; Lei, B.; Li, J.; Quan, J.; Liu, H. Identification and Evolutionary Analysis of Maize DUF1685 Gene Family. Chin. J. Trop. Crops 2022, 43, 2431–2442. [Google Scholar]
- Niu, X.; Wang, J.; Gao, Y.; Nan, J.; Zhang, C.; Li, S.; Xing, G. Identification and expression profiles of CBP60 family genes in cucumber (Cucumis sativus L.). J. Hebei Agric. Univ. 2023, 46, 8–18. [Google Scholar]
- Zhu, Y.; Zuo, S.; Chen, Z.; Chen, X.; Li, G.; Zhang, Y.; Zhang, G.; Pan, X. Identification of two major rice sheath blight resistance QTLs,qSBl-1(HJX74) and qSB11(HJX74),in field trials using chromosome segment substitution lines. Plant Dis. 2014, 98, 1112–1121. [Google Scholar] [CrossRef]
- Chen, X.; Chen, Y.; Zhang, L.; Xu, B.; Zhang, J.; Chen, Z.; Tong, Y.; Zuo, S.; Xu, J. Overexpression of OsPGIPl enhances rice resistance to sheath blight. Plant Dis. 2016, 100, 388–395. [Google Scholar] [CrossRef]
- He, M.; Yin, J.; Feng, Z.; Zhu, X.; Zhao, J.; Zuo, S.; Chen, X. Methods for Evaluation of Rice Resistance to Blast and Sheath Blight Diseases. Chin. Bull. Bot. 2020, 55, 577–587. [Google Scholar]
- Liu, F.; Liu, H.; Huang, F.; Li, M.; Cao, Y.; Luo, C.; Li, J. Influence of GAFP Gene Introduction on Disease Resistance, Agronomic and Economic Characters of Colored-Cotton. Chin. Agric. Sci. Bull. 2006, 22, 57–59. [Google Scholar]
- Shen, H.; Wang, A.; Li, Y.; Zhu, J. Study on the Characteristics of Transgenic (GAFP) Xinjiang Upland Cotton. J. Yunnan Agric. Univ. 2015, 30, 1–8. [Google Scholar]

| Line | Heading Date (d) | Plant Height (cm) | Panicle Length (cm) | Flag Leaf Length (cm) | Flag Leaf Width (cm) | Panicle Number per Plant | Grain Number per Panicle | Filled Grain Rate (%) | 1000-Grain Weight (g) | Grain Yield per Plant (g) |
|---|---|---|---|---|---|---|---|---|---|---|
| XD3 | 95.0 ± 0.00 | 84.1 ± 0.50 | 18.9 ± 0.26 | 23.8 ± 0.72 | 1.5 ± 0.17 | 10.0 ± 1.00 | 105.3 ± 3.51 | 91.8 ± 1.75 | 26.8 ± 0.36 | 25.0 ± 2.80 |
| XD-G1 | 94.0 ± 0.89 | 83.9 ± 1.59 | 18.5 ± 0.58 | 23.4 ± 0.87 | 2.4 ± 0.20 * | 11.0 ± 2.00 | 110.0 ± 7.04 | 93.4 ± 0.26 * | 26.2 ± 0.50 | 27.7 ± 4.91 |
| XD-SG1 | 92.5 ± 0.00 * | 83.3 ± 0.42 | 19.1 ± 0.69 | 19.4 ± 1.06 ** | 1.5 ± 0.18 | 10.5 ± 1.05 | 104.5 ± 9.14 | 92.3 ± 1.51 | 27.1 ± 0.38 | 25.9 ± 2.43 |
| XD-G2 | 94.2 ± 0.41 | 84.9 ± 0.98 | 22.5 ± 0.40 * | 23.3 ± 0.72 | 1.5 ± 0.17 | 9.5 ± 1.52 | 105.3 ± 5.96 | 92.2 ± 0.46 | 26.8 ± 0.40 | 24.0 ± 4.47 |
| XD-SG2 | 94.2 ± 0.41 | 81.1 ± 0.92 * | 19.0 ± 0.81 | 24.0 ± 0.79 | 1.4 ± 0.13 | 9.0 ± 1.41 | 107.5 ± 7.01 | 90.8 ± 1.45 | 26.7 ± 0.51 | 22.4 ± 3.85 |
| XD-G3 | 95.0 ± 0.63 | 84.4 ± 1.04 | 19.1 ± 0.36 | 23.6 ± 0.98 | 2.6 ± 0.13* | 10.5 ± 1.05 | 112.5 ± 3.64 * | 92.6 ± 1.33 * | 26.7 ± 0.41 | 25.3 ± 3.12 |
| XD-SG3 | 92.5 ± 0.63 * | 83.0 ± 0.83 | 23.5 ± 0.99 ** | 23.3 ± 0.74 | 1.6 ± 0.23 | 9.5 ± 1.05 | 102.5 ± 6.80 | 91.2 ± 1.62 | 26.5 ± 0.35 | 22.7 ± 3.43 |
| XD-G4 | 94.0 ± 0.00 | 88.0 ± 1.00 ** | 19.2 ± 0.46 | 24.8 ± 0.66 | 1.5 ± 0.14 | 8.5 ± 1.05 | 103.0 ± 4.10 | 91.5 ± 1.98 | 24.6 ± 0.51 * | 21.2 ± 1.69 ** |
| XD-SG4 | 94.0 ± 0.63 | 84.4 ± 1.14 | 15.4 ± 0.83 * | 26.3 ± 0.63 ** | 1.5 ± 0.24 | 9.7 ± 1.21 | 110.0 ± 8.10 | 92.6 ± 1.38 | 27.4 ± 0.26 | 22.3 ± 2.07 |
| Line | Heading Date (d) | Plant Height (cm) | Panicle Length (cm) | Flag Leaf Length (cm) | Flag Leaf Width (cm) | Panicle Number per Plant | Grain Number per Panicle | Filled Grain Rate (%) | 1000-Grain Weight (g) | Grain Yield per Plant (g) |
|---|---|---|---|---|---|---|---|---|---|---|
| R6547 | 91.0 ± 0.00 | 117.7 ± 0.30 | 23.6 ± 0.46 | 32.0 ± 0.40 | 2.3 ± 0.25 | 13.0 ± 1.00 | 158.0 ± 4.36 | 85.5 ± 3.46 | 24.8 ± 0.30 | 38.8 ± 2.25 |
| R-G1 | 90.5 ± 0.84 | 117.3 ± 1.42 | 24.5 ± 0.55 | 33.9 ± 0.70 | 2.6 ± 0.18 * | 13.0 ± 1.41 | 160.0 ± 6.26 | 85.8 ± 1.16 | 25.2 ± 0.37 | 39.0 ± 3.96 |
| R-SG1 | 91.0 ± 0.23 | 116.0 ± 1.73 | 21.3 ± 0.74 * | 33.8 ± 2.45 | 2.5 ± 0.22 | 11.5 ± 1.05 | 159.0 ± 6.99 | 86.1 ± 1.28 | 24.4 ± 0.63 | 36.8 ± 3.71 |
| R-G2 | 89.0 ± 0.34 * | 117.1 ± 0.63 | 23.2 ± 0.43 | 29.0 ± 0.24 * | 2.5 ± 0.19 | 14.3 ± 1.37 | 159.0 ± 2.61 | 85.8 ± 0.79 | 25.0 ± 0.35 | 39.7 ± 3.12 |
| R-SG2 | 90.5 ± 0.55 | 117.4 ± 0.94 | 23.2 ± 0.39 | 35.1 ± 1.61 * | 2.4 ± 0.32 | 13.5 ± 1.38 | 157.0 ± 6.63 | 84.8 ± 1.70 | 24.7 ± 0.53 | 38.5 ± 3.84 |
| R-G3 | 91.0 ± 0.63 | 113.6 ± 0.85 * | 21.2 ± 0.23 * | 31.3 ± 1.59 | 2.3 ± 0.17 | 14.0 ± 1.79 | 156.0 ± 8.72 | 86.8 ± 1.16 | 25.4 ± 0.63 | 40.6 ± 3.99 |
| R-SG3 | 88 ± 0.55 ** | 118.7 ± 1.68 | 24.8 ± 2.03 | 34.4 ± 2.31 | 2.4 ± 0.10 | 12.5 ± 1.87 | 157.5 ± 8.24 | 83.2 ± 1.87 * | 24.9 ± 0.24 | 36.9 ± 4.20 |
| R-G4 | 90.5 ± 0.84 | 119.3 ± 1.28 | 24.5 ± 0.63 | 32.7 ± 0.61 | 2.4 ± 0.21 | 13.5 ± 1.05 | 155.0 ± 5.97 | 87.1 ± 1.08 | 24.4 ± 0.50 | 38.7 ± 1.80 |
| R-SG4 | 92.0 ± 0.00 | 122.8 ± 0.59 ** | 23.8 ± 0.68 | 29.8 ± 0.70 | 2.1 ± 0.24 | 15.0 ± 1.55 | 156.0 ± 4.10 | 87.8 ± 0.24 | 25.8 ± 0.21 * | 39.6 ± 0.26 |
| Line | Grain Length (cm) | Grain Width (cm) | Chalkiness Rate (%) | Chalkiness Degree (%) | AC (%) |
|---|---|---|---|---|---|
| XD3 | 0.70 ± 0.030 | 0.36 ± 0.026 | 18.7 ± 0.50 | 3.7 ± 0.36 | 18.4 ± 0.75 |
| XD-G1 | 0.71 ± 0.023 | 0.35 ± 0.017 | 17.3 ± 0.24 ** | 3.8 ± 0.36 | 18.0 ± 0.73 |
| XD-SG1 | 0.73 ± 0.031 | 0.36 ± 0.024 | 16.9 ± 0.59 ** | 3.6 ± 0.24 | 18.0 ± 0.43 |
| XD-G2 | 0.69 ± 0.030 | 0.35 ± 0.020 | 18.8 ± 0.62 | 3.8 ± 0.62 | 16.6 ± 0.55 ** |
| XD-SG2 | 0.69 ± 0.024 | 0.35 ± 0.030 | 18.3 ± 0.24 | 3.6 ± 0.62 | 18.0 ± 0.74 |
| XD-G3 | 0.70 ± 0.015 | 0.36 ± 0.014 | 18.9 ± 0.58 | 3.1 ± 0.32 | 17.5 ± 0.25 * |
| XD-SG3 | 0.73 ± 0.028 | 0.34 ± 0.014 | 18.8 ± 0.37 | 5.9 ± 0.74 * | 18.3 ± 0.73 |
| XD-G4 | 0.62 ± 0.014 * | 0.35 ± 0.010 | 18.6 ± 0.32 | 3.6 ± 0.91 | 18.5 ± 0.49 |
| XD-SG4 | 0.73 ± 0.026 | 0.34 ± 0.020 | 18.8 ± 0.78 | 3.6 ± 0.50 | 18.1 ± 0.64 |
| Line | Grain Length (cm) | Grain Width (cm) | Chalkiness Rate (%) | Chalkiness Degree (%) | AC (%) |
|---|---|---|---|---|---|
| R6547 | 0.89 ± 0.030 | 0.24 ± 0.026 | 16.5 ± 0.75 | 1.8 ± 0.35 | 14.2 ± 0.35 |
| R-G1 | 0.83 ± 0.020 * | 0.24 ± 0.010 | 14.8 ± 0.37 * | 1.9 ± 0.55 | 13.3 ± 0.51 |
| R-SG1 | 0.89 ± 0.028 | 0.24 ± 0.026 | 16.4 ± 0.64 | 1.7 ± 0.36 | 14.0 ± 0.64 |
| R-G2 | 0.92 ± 0.024 | 0.23 ± 0.014 | 16.5 ± 0.42 | 2.7 ± 0.27 ** | 14.0 ± 0.40 |
| R-SG2 | 0.91 ± 0.023 | 0.23 ± 0.015 | 16.9 ± 0.37 | 1.9 ± 0.32 | 13.8 ± 0.24 |
| R-G3 | 0.90 ± 0.028 | 0.24 ± 0.014 | 17.9 ± 0.28 * | 2.0 ± 0.45 | 14.4 ± 0.53 |
| R-SG3 | 0.82 ± 0.016 * | 0.22 ± 0.014 | 16.9 ± 1.47 | 2.8 ± 0.34 ** | 13.9 ± 0.82 |
| R-G4 | 0.91 ± 0.024 | 0.24 ± 0.009 | 16.6 ± 1.04 | 1.7 ± 0.31 | 13.6 ± 0.68 |
| R-SG4 | 0.89 ± 0.032 | 0.23 ± 0.015 | 16.7 ± 1.18 | 1.6 ± 0.24 | 13.8 ± 0.24 |
Disclaimer/Publisher’s Note: The statements, opinions and data contained in all publications are solely those of the individual author(s) and contributor(s) and not of MDPI and/or the editor(s). MDPI and/or the editor(s) disclaim responsibility for any injury to people or property resulting from any ideas, methods, instructions or products referred to in the content. |
© 2023 by the authors. Licensee MDPI, Basel, Switzerland. This article is an open access article distributed under the terms and conditions of the Creative Commons Attribution (CC BY) license (https://creativecommons.org/licenses/by/4.0/).
Share and Cite
Zhu, J.; Xue, X.; Ju, R.; Zhao, J.; Liu, F.; Han, X.; Yan, Y.; Wang, Y.; Feng, Z.; Lin, D.; et al. Ectopic Expression of Gastrodia Antifungal Protein in Rice Enhances Resistance to Rice Sheath Blight Disease. J. Fungi 2024, 10, 33. https://doi.org/10.3390/jof10010033
Zhu J, Xue X, Ju R, Zhao J, Liu F, Han X, Yan Y, Wang Y, Feng Z, Lin D, et al. Ectopic Expression of Gastrodia Antifungal Protein in Rice Enhances Resistance to Rice Sheath Blight Disease. Journal of Fungi. 2024; 10(1):33. https://doi.org/10.3390/jof10010033
Chicago/Turabian StyleZhu, Junkai, Xiang Xue, Ran Ju, Jianhua Zhao, Fen Liu, Xian Han, Yu Yan, Yu Wang, Zhiming Feng, Dongmei Lin, and et al. 2024. "Ectopic Expression of Gastrodia Antifungal Protein in Rice Enhances Resistance to Rice Sheath Blight Disease" Journal of Fungi 10, no. 1: 33. https://doi.org/10.3390/jof10010033
APA StyleZhu, J., Xue, X., Ju, R., Zhao, J., Liu, F., Han, X., Yan, Y., Wang, Y., Feng, Z., Lin, D., Chen, Z., Wang, Y., Chen, X., Chu, C., Zuo, S., & Zhang, Y. (2024). Ectopic Expression of Gastrodia Antifungal Protein in Rice Enhances Resistance to Rice Sheath Blight Disease. Journal of Fungi, 10(1), 33. https://doi.org/10.3390/jof10010033

